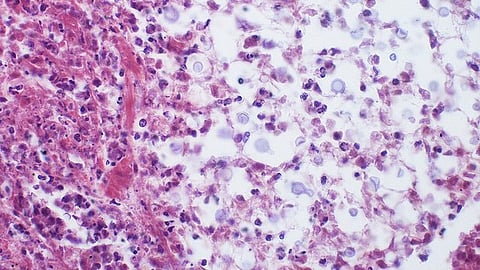
Cryptococcosis is a fungal infection of mainly the lungs that might lead to meningitis. (Representational Image: Wikimedia commons)

A group of international mycology experts led by Professor Dr Oliver A. Cornely at the University of Cologne has jointly drafted a guideline for the diagnosis and treatment of cryptococcosis, which aims at improving infection management and thus the survival rate of patients. Cryptococcosis is a fungal infection of mainly the lungs that might lead to meningitis. The article ‘Global guideline for the diagnosis and management of cryptococcosis’ was published in the journal The Lancet Infectious Diseases.
Cryptococcosis, especially cryptococcal meningitis (CM) as the most fatal form, is responsible for a high fatality rate among patients. It is one of the most widespread invasive fungal infections in the world and is a major threat particularly to people suffering from immunodeficiencies. For example, around one million cases of cryptococcal meningoencephalitis are diagnosed worldwide every year in people with HIV alone, and more than 600,000 people die from the disease each year. Patients who have undergone a bone marrow transplant or organ transplant are also at high risk of infection. It is transmitted through the inhalation of spores from soil. Other organs are then also infected via the bloodstream. The lungs, brain, skin and bones are most frequently affected.
Invasive fungal infections are often difficult to recognize in everyday work in clinics because they occur so rarely. However, it is particularly important for patients at risk to be treated quickly and appropriately
Dr Oliver A. Cornely, Department of Internal Medicine at University Hospital Cologne and Director of the Institute of Translational Research at the University of Cologne’s CECAD Cluster of Excellence for Aging Research
“Invasive fungal infections are often difficult to recognize in everyday work in clinics because they occur so rarely. However, it is particularly important for patients at risk to be treated quickly and appropriately,” said Cornely from Department I of Internal Medicine at University Hospital Cologne and Director of the Institute of Translational Research at the University of Cologne’s CECAD Cluster of Excellence for Aging Research. “At the same time, we must not forget that the conditions for recognizing the infection at an early stage are not equally good everywhere in the world and that resources are sometimes very limited. There are many countries with a high number of cases that are poorly equipped in this respect. As part of our Global Guideline Programme, we would like to contribute to improving this situation.”
The cryptococcosis guideline is designed to support medical staff in handling invasive fungal infections. It is intended to provide practical guidance and support in decision-making and thus improve clinical approaches, diagnosis, management, and aftercare for the benefit of patients.
The project was carried out by the mycological societies ECMM (European Confederation of Medical Mycology) and ISHAM (International Society for Human and Animal Mycology) in collaboration with the ASM (American Society for Microbiology). “More than 70 other international specialist institutions were involved in developing this new guideline. This is a great help for our scientific work and shows how great the interest, but also the need for such recommendations is,” explained Cornely. Authors from 22 countries contributed to this guideline. Dr Christina Chang from Monash University in Melbourne, Australia, and Professor Dr John Robert Perfect from Duke University in Durham, USA, were in charge of the project.
Invasive fungal infections are emergencies. However, as a single pathogen often only occurs very rarely, it is often only discovered late. But patients' lives depend on rapid detection and well-practised procedures. Since 2017, University Hospital Cologne has been home to one of the European Centres of Excellence recognized by the ECMM. At the centre, patients have access to modern testing procedures and treatment options. In addition, the experts under the direction of Professor Cornely serve as advisory contacts for colleagues in Germany and abroad. (SB/Newswise)